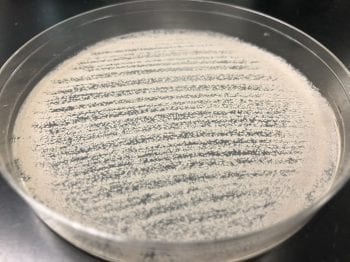
Mildew looks powdery

If you’ve been reading the blog, you know what mold is and how to spot it; but, mold is not the only microscopic pest that may be inhabiting your home.
Mildew, another type of fungi, is the lesser of two evils. Many people cannot tell the difference between mold and mildew, but we are here to help!
While mold and mildew have many similarities, including the environment in which each can grow and thrive, there are plenty of differences that can range from substantial risks to human health to damages made to your property.
Mold & Mildew Similarities
Mold and mildew both thrive in moist, humid environments where a light source is either scarce or non-existent.
Both microorganisms grow when their spores (or seeds) find their way into suitable conditions for a colony to begin expanding.
These conditions require porous, organic material to live from like wood, fabric, paper, clothing, food, etc., but neither is very often found growing on synthetic materials such as plastic or metal-based products.
Most commonly in the household, mold and mildew are found in kitchens, bathrooms, basements, crawl spaces, attics, and garages.
Extended exposure to mold and mildew can carry some unpleasant health effects. Respiratory issues and headaches can both be symptoms of contact with mold or mildew.
Mold & Mildew Differences
The most noticeable difference between mold and mildew are in what the human eye can pick up – appearances.
Mold can range in colour from black or white to yellow, green, and even pink.
Mildew appears in more earthy colours like brown and yellow, but can also appear white, grey, or black.
Texture-wise, mold tends to look slimy or fuzzy, while mildew appears to be powdery.
[caption id="attachment_3328" align="alignright" width="350"]
Mold looks fuzzy
[caption id="attachment_3337" align="alignleft" width="350"]

Mildew looks powdery

Found Mold or Mildew in your Home? Here's What to Do
Most importantly, you need to understand the dangers of extended mold and mildew exposure. Serious health issues like asthma can be triggered by contact or exposure to these types of fungus.

Learn more about us or contact us for more information.